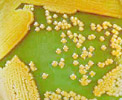

白絹病
灰黴病
炭疽病
疫病
細菌性軟腐病
褐斑病
石斛蘭葉斑病
東亞蘭嵌紋病毒
齒舌蘭輪斑病毒
胡瓜嵌紋病毒 |
褐斑病 (Brown spot) 病原菌:Pseudomonas
cattleyae (Pavarino) Savulescu 1947
(Syn:Acidovorax avenae subsp. cattleyae)
蘭花褐斑病最早發現於義大利及美國加州,1950
年間即在加州蘭園內普遍為害蝴蝶蘭及嘉德麗亞蘭,隨後菲律賓也有為害蝴蝶蘭的報導,主要發生於七至十月間的雨季。蘭花褐斑病何時傳入臺灣已不可考,近一、二十年來我國蝴蝶蘭經濟栽培規模大幅擴增,蘭花溫室中溫暖、潮濕的環境正適於本病發生,近十餘年來,褐斑病與軟腐病已成為臺灣蝴蝶蘭上最普遍而嚴重的細菌性病害。
病徵:
主要危害葉片。該菌感染蝴蝶蘭後,可在葉片上首先出現水浸狀小斑點,後來逐漸擴大,有些成不規則褐色或黑褐色壞疽病斑,周圍具明顯黃暈,有些則繼續擴展,成為橢圓形或長條形水浸狀褐色或黑褐色斑塊或斑條,發病嚴重時導致整葉黃化或乾枯。
病菌可以感染各齡期蝴蝶蘭葉片的不同部位,病徵因寄主品系、發病條件不同而有差異。典型病徵為葉片受感染後首先出現淡褐色水浸狀斑點,隨後擴大成為褐、暗褐或黑色的不規則凹陷壞疽斑,周圍具明顯黃暈,病斑可相互融合成為大斑塊;有些感染則會繼續擴展,成為橢圓、長條形或不規則形的深綠色或黑褐色大型水浸狀斑,病斑周圍通會出現墨綠色環紋,以手觸摸病斑處仍覺堅硬,與軟腐病頗不相同,濕度高時如病斑破裂,常可見溢出乳白色的菌泥,罹病葉片最後黃化乾枯,病勢如擴展到生長點,則導致整株死亡。幼苗如遭受感後,則迅速軟腐而壞死,病徵與軟腐病或黑腐病近似。
病原菌:
|
分 類: |
屬於原核菌 (Procaryote),假胞菌科
(Pseudomonaceae)。為革蘭氏陰性,不產生螢光色素,好氣 (aerobic) 細菌。1992 年
Willems 氏等建議將本菌更名為 Acidovorax avenae subsp.
cattleyae。 |
|
分 佈: |
世界上有關本病的報導甚少,目前僅美國、義大利、菲律賓、中國大陸及臺灣有發生的記錄。該病在我國各地蘭園普遍發生。 |
|
寄 主: |
該菌除可感染蝴蝶蘭外,也可感染嘉德麗亞蘭、文心蘭、狐狸尾蘭、春石斛、秋石斛、千代蘭、朵麗蝶蘭、拖鞋蘭、樹蘭 (Epidendrum
o'reinianum ) 及香草蘭 (Vanilla)。 |
|
形 態: |
菌體為棍棒狀,大小為
0.5-1.0×2.0 mm,具 1-2 單極生鞭毛。在 King's B 或 Pseudomonas Agar F
培養基上形成乳白色略凸起的菌落 。 |
|
診斷技術: |
褐斑病有壞疽斑及水浸狀斑二種病徵,壞疽斑周圍的黃暈或水浸狀斑的堅硬觸感與泌出菌泥,是肉眼初步鑑別該病的依據,進一步則可切取病斑與健部交界處小塊組織,置於載玻片上的水滴中,覆上蓋玻片,直接在光學顯微鏡下檢視,如發現成群或成團微小的游動菌體自組織中湧出,可確認其為細菌性病害。欲分離該菌時可以用75%酒精擦拭病斑與健部交界表面後,將病斑與健部交界處組織於無菌水中磨碎,將磨出液畫線於含
0.25% 葡萄糖的營養培養基 (nutrient agar)、King's B或 Pseudomonas Agar F
上,如為褐斑病則 2-3 天後通常會出現純度頗高的病菌菌落,病菌可製備成每毫升約含 107-108
細胞的懸浮液,用於注射菸草葉片,如確為本病菌,則於 24 小時內可見被注射組織崩解的過敏性反應 。 |
|
生 活
史: |
本病的生活史迄今無詳細研究,但本病一旦發生,即使剪除病葉,仍容易出現新的感染,由此推斷該菌應可在蝴蝶蘭或其他植物表面存活一段較長時期,俟環境適宜時由葉片傷口或自然開口侵入感染。 |
發病生態:
在病原菌於20~32℃間生長良好,最適溫度約28℃,最高約40℃,最低約12℃,因此在溫暖、高濕環境下最容易發病。濕度高時或以手觸摸水浸狀病斑處,會溢出許多乳白色菌泥,內含極多具有感染力之細菌。與軟腐性病害最大的不同是罹病葉片之組織仍覺堅硬,病葉亦可保持原姿。
傳播途徑:
病原細菌藉葉面澆水、噴霧或施肥而散播至健株上,造成二次感染。
防治方法:
| 一、 |
藥劑防治: |
|
1.
|
用30.3%「四環黴素」可溶性粉劑1000倍的效果最好。 |
|
2.
|
77%氫氧化銅可濕性粉劑400倍。 |
|
3.
|
40%銅快得寧可濕性粉劑400倍。 |
|
4.
|
39%硫酸快得寧可濕性粉劑400倍。 |
|
5.
|
81.3%嘉賜銅可濕性粉劑1000倍。 |
| 二、 |
在防治軟腐病時,也同時可防治褐斑病,因此不必再額外施藥,而這些藥劑除可用於全面噴灌外,其濃厚液也可用於塗抹切除病患部的傷口,以防止病害繼續擴展。不過,大多數菌株對多保鏈黴素及鏈黴素具有抗藥性,以該兩藥劑施行防治之效果不理想。
(黃聰昌、李惠玲,1991,興農273期第85頁) |
|
三、 |
栽培防治法:
參照防治軟腐病的措施,選用清潔的栽培質材,清除病株及蘭園雜草並避免混植其他植物,以減少感染源;保持適當植株間距,以防葉片摩擦造成傷口;勿過度噴灌並維護蘭園適度通風,避免葉片積水,以減少病菌感染與散播;適量的氮素及充足的陽光以增進植株抵抗性,都是預防本病的重要措施。 |
|
四、 |
化學防治:
本病目前並無正式推薦的化學防治藥劑,但據試驗30.3% 四環黴素可溶性粉劑1,000 倍、77%
氫氧化銅可濕性粉劑 400 倍及 16.5%
滅紋乳劑均有顯著的預防效果,其中又以四環黴素的效果最突出。在臺灣鏈黴素對少數的褐斑病菌株,雖仍有顯著的抑制效果,但
70-80% 的菌株已具抗藥性,其抗藥程度超過 3,000 ppm,因此以含鏈黴素的製劑施行防治,通常收不到效果。 |
參考文獻:
|
1.
|
位國慶。1994。臺灣蝴蝶蘭真菌及細菌病害之發生與防治。中華植物保護學會特刊新二號。119-131頁。中華植物保護學會編印。 |
|
2.
|
許秀惠。1994。臺灣花卉之細菌病害。中華植物保護學會特刊新二號。63-75頁。中華植物保護學會編印。 |
|
3.
|
謝式拌鈺。1986。蘭花細菌性病害:軟腐病與褐斑病。興農
222:27-30。 |
|
4.
|
Ark, P.A., and Thomas, H.
E. 1946. Bacterial leaf spot and bud rot of orchids caused
by Phytomonas cattleyae. Phytopathology 36:695-698. |
|
5.
|
Ark, P.A., and Starr, M.
P. 1951. Bacterial diseases of orchids. Plant Dis. Reptr.
35:42-43. |
|
6.
|
Quimio, A. J., and Tabei,
H. 1979. Identity of the bacterium associated with bacterial
brown spot of Phalaenopsis orchids. Philipp.
Phytopathol. 15:76-80. |
|
7.
|
Bradbury, J. F. 1986.
Guide to Plant Pathogenic Bacteria. C.A.B. International,
UK. 331pp. |
|
8.
|
Huang, T. C. 1990.
Characteristics and control of Pseudomonas cattleyae
causing brown spot of Phalaenopsis orchid in Taiwan.
Plant Prot. Bull. 32:327.(Abstr.) |
|
9.
|
Willems, A., Goor, M.,
Thielemans, S., Gillis, M., Kersters, K. Ley, J. De., and De
Ley, J. 1992. Transfer of several phytopathogenic
Pseudomonas species to Acidovorax as
Acidovorax avenae subsp. avenae subsp. nov.,
comb. nov., Acidovorax avenae subsp. citrulli,
Acidovorax avenae subsp. cattleyae, and
Acidovorax konjaci. Int. J. Syst. Bacteriol. 42:107-119. |
|
|
 |
|
 |
|
水浸狀長條斑 |
|
壞疽病斑型 |
( 、李惠鈴,1991,興農273期87頁) 、李惠鈴,1991,興農273期87頁) |
|
( 、李惠鈴,1991,興農273期87頁) 、李惠鈴,1991,興農273期87頁) |
 |
|
 |
| 褐斑病病斑 |
|
擴大的病斑 |
( 、李惠鈴,1991,興農273期87頁) 、李惠鈴,1991,興農273期87頁) |
|
( 、李惠鈴,1991,興農273期87頁) 、李惠鈴,1991,興農273期87頁) |
 |
|
 |
| 葉背的病斑邊緣墨綠色 |
|
嚴重的大型病斑 |
| (位國慶,1994,農藥世界134期41頁) |
|
(位國慶,1994,農藥世界134期41頁) |
病斑2.jpg) |
|
 |
| 葉背病斑 |
|
初期水浸狀病斑 |
( 、李惠鈴,1991,興農273期87頁) 、李惠鈴,1991,興農273期87頁) |
|
(位國慶,1994,農藥世界134期41頁) |
 |
|
 |
| 長條狀病斑 |
|
褐斑病壞疽型病斑 |
| (位國慶,1994,農藥世界134期41頁) |
|
|
|
|
|
|
褐斑病菌典型菌落 |
|
|
(動植物防疫檢疫局,2000,植物保護圖鑑系列6,第51-56頁)
|